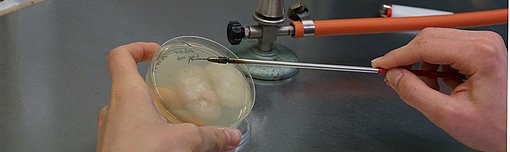

Laborant/in EFZ - Biologie ¶
Du hast Freude an den Naturwissenschaften? Du arbeitest gerne an der Laborbank und hast keine Probleme im Umgang mit Computer? Du fühlst dich wohl im Team und führst deine Aufgaben selbständig aus? Die WSL bietet dir eine fundierte Grundausbildung zu Laborant/in EFZ Biologie an.

In dieser dreijährigen Ausbildung wirst du in die Insektenkunde (Entomologie), in Arbeiten mit DNA (molekulare Biologie) und Mikroben (Mikrobiologie) sowie in die Welt der Pflanzenkrankheiten (Phytopathologie) eingeführt. In der Umweltforschung lernst du alles, was im Labor wichtig ist: mikroskopieren, Lösungen herstellen, steriles Arbeiten, Mikroben vermehren, PCR pipettieren, DNA sequenzieren, Geräte und Computer bedienen und vieles mehr. Du wirst auch im Feld draussen in der Natur arbeiten und Grundlagen über die Biodiversität, einheimischen Insekten, Waldbäume und Pflanzenkrankheiten lernen. Die Theorie dazu bekommst du während zwei Tagen pro Woche in der Berufsschule in Winterthur vermittelt. Zusätzlich besuchst du zwei externe Einführungskurse im ETH-Lehrlabor in Zürich. Die WSL unterstützt dich, wenn du die Berufsmittelschule (BMS) lehrbegleitend besuchen willst. Die BMS kann aber auch nach der Lehre absolviert werden.
Deine persönlichen Voraussetzungen ¶
- Sekundarschule A mit guten Leistungen in Mathematik, in den Naturwissenschaften, in Deutsch und Englisch
- Theoretisches und praktisches Interesse für Biologie und Chemie
- Logisches Denken und Vorstellungsvermögen, manuelle Geschicklichkeit und Ausdauer
- Gute Beobachtungs- und Auffassungsgabe, Sorgfalt, selbständiges und zuverlässiges Arbeiten
- Freude am Arbeiten in einer technisierten und komplexen Arbeitsumgebung